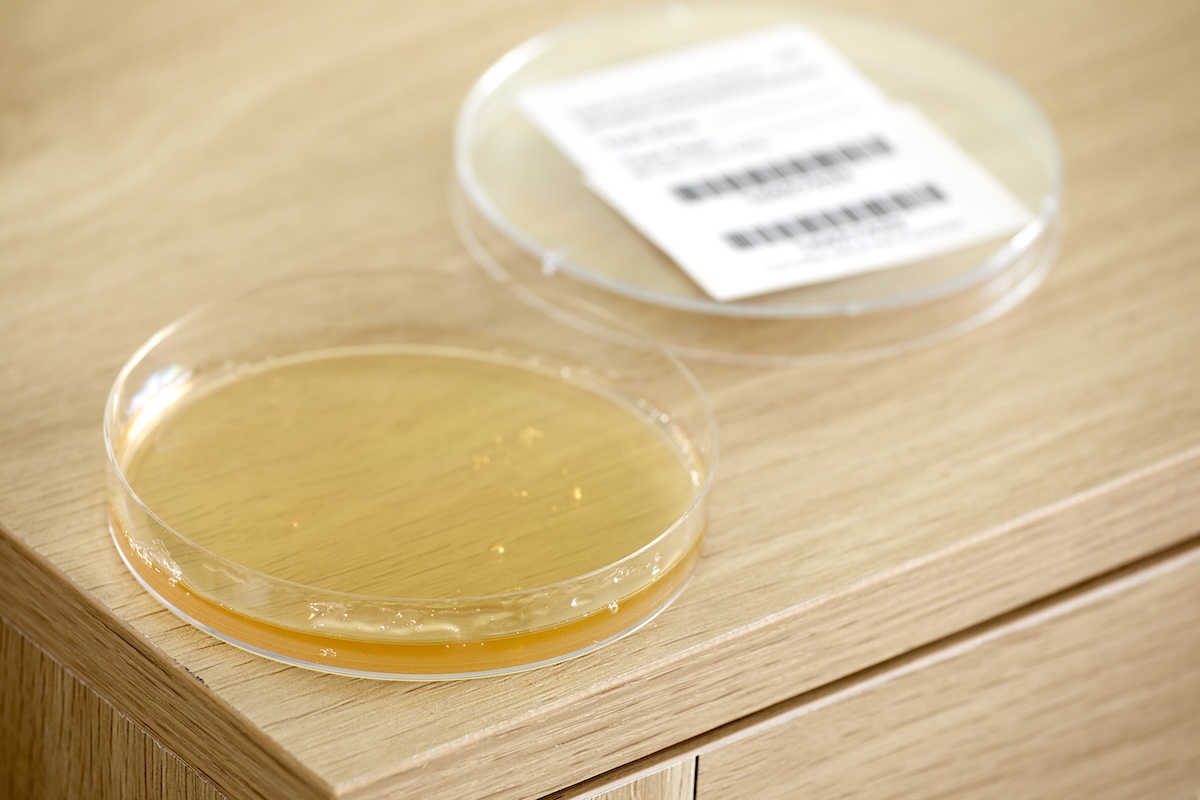
Open petri dish with minimal spores in gel fluid inside dish, lid next to dish.

We may earn revenue from the products available on this page and participate in affiliate programs. Learn More ›
Project Overview
- Mold is primarily found in high-moisture areas like kitchens and bathrooms, and anywhere that has experienced flooding or leaks.
- Homeowners can test for mold using a DIY kit but will need to send the results to a lab to determine the type of mold present.
- Left unattended, mold can become a health hazard for the residents of a home, so it’s vital to address the problem right away.
- A professional mold remediation company can get rid of the mold quickly, allowing homeowners to enjoy their space worry-free.
Mold thrives in damp areas like bathrooms, basements, and kitchens, and while it plays an important role outdoors, its presence indoors can harm both your home and your health. Airborne spores can trigger allergies, asthma, or other respiratory issues, so it’s important to know whether mold is lurking in your living spaces.
Sometimes a musty odor comes with visible signs, like discolored spots on walls, warped flooring, or persistent humidity. Other times, there may be no clear indications. If you’re worried about indoor air quality, testing for mold can help confirm whether spores are present and guide you toward the right solution.
How Mold Testing Works
Mold testing helps identify whether spores are present in your home’s air or on surfaces, and in some cases, what type of mold you’re dealing with. Most at-home kits include collection plates or swabs that gather samples from the air or from suspected problem areas. After collecting samples, you can either review initial results at home or send them to a lab for detailed analysis.
You can find mold test kits online, at hardware stores, or in home improvement centers. While these kits aren’t a substitute for professional testing, they can provide valuable insight into whether mold is affecting your indoor environment. If results suggest a significant problem, hiring a certified mold inspector might be the next step to confirm the source and determine the best treatment plan.
Signs of Mold Exposure

Mold exposure can affect both your health and your home, and in many cases, symptoms appear before mold is visible. If you notice any of the following, it could be time to test for mold:
Health symptoms:
- Frequent sneezing, coughing, or congestion
- Itchy or watery eyes
- Worsening asthma or allergy symptoms
- Headaches or unexplained fatigue
- Skin irritation or rashes
- Diminished ability to concentrate
Home warning signs:
- Persistent musty odors
- Dark spots or stains on walls, ceilings, or grout
- Warped or bubbling drywall and paint
- High indoor humidity or condensation
Testing can help confirm whether mold is causing these problems, and guide you toward the best solution.
Before You Begin
Mold needs moisture to grow, which is why it’s most often found in damp, humid areas like bathrooms, basements, or anywhere plumbing leaks have occurred. If mold is visible, testing isn’t necessary, cleanup or professional removal is the next step.
What about mold you can’t see? A persistent musty odor without obvious spots or stains may point to hidden growth behind walls, under flooring, or in other concealed areas. In these situations, testing can help confirm whether mold is present. Just be sure to follow safety precautions, since spores can become airborne when disturbed. According to Karen Peissinger, industrial hygiene generalist at the University at Buffalo, “Mold testing is not necessary in the vast majority of cases. If mold is visible, it should be cleaned up properly.” She recommends consulting Environmental Protection Agency (EPA) guidelines to find out how to remove mold safely.
Safety Tips
- The EPA does not endorse any specific brand of mold detection kit. If you suspect a significant or widespread problem, the EPA recommends hiring licensed professionals for assessment and remediation. Ideally, the inspector should be independent from the company that performs the cleanup.
- Anyone can suffer from the effects of exposure to mold spores, but the risk of health problems increases for those with known allergies, compromised immune systems, and respiratory disorders, even if the home has been allergy-proofed.
- Watch for symptoms and signs of mold exposure such as respiratory problems, headaches, or itching when testing or cleaning.
- When handling or cleaning mold, it’s a good idea to wear gloves, goggles, and a mask for protection.
How to Test for Mold Using a Test Kit

Home mold test kits are available at most hardware stores and online so that you can check for mold yourself. The process usually takes a few days: You’ll collect samples from surfaces or the air, allow the kit to develop, and then check the results. If the test indicates mold growth, you can send the sample to a lab for a more detailed report, though this report may cost an extra fee.
Tools & Materials
Bobvila.com may earn a commission from purchases made through these links.
Step 1: Close off the space.

Close the windows and doors in the room you’ll be testing 24 hours before performing the test. This allows potential mold spores to congregate without being disturbed by drafts to properly check the air quality for mold.
Step 2: Set up the test kit.

Remove the contents of the kit from its packaging. Typically, you’ll find at least a shallow plastic or glass petri dish with a lid and a label. The inside of the petri dish has been treated with a substance known as a “microbial culture” that promotes the growth of mold spores. This should help you collect an adequate sample when testing for mold in the amount of time recommended by the manufacturer.
Step 3: Leave the petri dish alone for a few days.

Remove the lid from the petri dish and place the dish (open end upward) on a flat surface at about table height.
Leave the petri dish untouched for about 48 hours. This time may vary slightly depending on the manufacturer’s instructions. During this time, restrict traffic in the room during the test period if possible to keep from disturbing the air. Cover the doorway with a strip of painter’s tape, if you need to, as a reminder to household members and guests that this area is temporarily off limits.
Step 4: Seal the petri dish and stow it in a dark space.

Place the lid back on the petri dish after the waiting time has passed, and put a layer of tape around the seam where the lid meets the dish. Either transparent tape or electrical tape works well, but avoid using a tape that’s difficult to remove, such as duct tape.
Write today’s date on the label enclosed in the kit, and affix the label to the bottom of the petri dish. Place the taped petri dish in a dark spot, such as a dresser drawer or on a closet shelf.
Step 5: Observe whether mold appears in the dish.
Check the petri dish in 2 days for signs of mold growth within the dish. If mold is present, it will look similar to the mold you’d find growing on old food in the fridge.
- If the petri dish shows no signs of mold, return it to the dark spot and check it again daily. If your test for mold turns up nothing after a total of 5 days (from the date on the label), you can throw the dish in the trash—the kit did not detect mold in the room.
- If mold is present in the dish, you can send the petri dish to the lab recommended by the manufacturer to determine the type of mold you have and the course of treatment. Many kits include an envelope for mailing, and you’ll also have to send payment for the analysis.
Step 6: Consider additional tests as you wait for professional results.
Allow 3 to 8 weeks to receive your results. Meanwhile, you may wish to continue testing for mold throughout the house. While a variable mold test can tell you if mold spores are present in a specific room, you’ll need to use additional kits if you want to test other rooms in your house. It may be worthwhile to look into who to call for a mold inspection if you suspect that the problem is extensive.
Since there is a wide range of potential health problems associated with mold, it is important to take steps to detect mold in your home quickly and remove it promptly. Follow the steps outlined above for how to test for mold to help you and others in the home breathe more easily. You can also consider investing in a good air quality monitor to provide additional reassurance that the air in your home is free of mold and other harmful pollutants.
Where to Look for Signs of Mold in Your Home

Mold’s location in your home can often provide clues as to its cause. For example, mold on a window sill can indicate that the window is not sealed properly, leading to leaks. The following are some of the most common spots for mold to grow undetected and are thus smart locations to test for mold:
- Behind the refrigerator
- Under stacks of newspapers or cardboard
- Behind the drywall in wall stud spaces that contain plumbing lines
- Under sinks
- Behind the wallboard around leaking windows
- In ventilation ducts
- Under carpeting that was wet at one time (flooding, carpet cleaning)
- On the back side of acoustic ceiling tiles (if the roof leaked)
- Behind any drywall that has been affected by a home flood
Tips for Getting Rid of Mold
-
- After removal, the best way to prevent mold and mildew is to reduce the home’s humidity and eliminate any water leaks.
-
- You can kill mold with a few common household products such as vinegar or a mixture of baking soda and water.
-
- For mold growth that exceeds 10 square feet, the EPA recommends professional cleanup. Professional mold remediation costs $2,252 on average.
-
- After removal, the best way to prevent mold and mildew is to reduce the home’s humidity and eliminate any water leaks.
The Most Common Types of Household Mold

While there are thousands of species of mold in existence, most homeowners are concerned about Stachybotrys chartarum, commonly known as toxic mold or black mold. This species of mold is actually quite rare, but it’s one of a number of molds that produce a high level of mycotoxins (dangerous mold-based chemicals) that can create a hazardous home environment. That said, any species of mold can become a health risk if it’s allowed to grow out of control.
“All molds have the potential to cause reactions in those individuals who are susceptible to mold [such as those who have allergies or respiratory disorders],” says Peissinger. “Also, that susceptibility can range from no reaction to a severe reaction, just like with dog and cat allergies. Thus, cleaning up any mold using proper methods is important.” To be on the safe side, treat and immediately remove all mold growth identified by a viable mold test.
Below are some of the more common types of mold that can be found in a home.
- Mucormycetes: Mucormycetes fungi, including Cunninghamella bertholletiae, Rhizomucor species, and Syncephalastrum species, are most commonly found in the soil during the summer and fall. It is difficult to avoid mucormycetes completely, and people with robust immune systems are generally not bothered by it. According to the CDC, however, murcomycosis—a fungal infection that affects the sinuses and lungs—can be very dangerous for those with weak immune systems.
- Alternaria: Alternaria alternata is an allergy-causing mold that is prevalent in the environment and can be brought into a home from the outdoors. It is dark in color and has a velvety texture. Once inside, it can spread quickly through the home, so prompt removal using a cleanser with bleach is important.
- Aspergillus: While most prevalent in the air, Aspergillus can also be found in soil, compost piles, stored grains, and decaying plants. Once brought inside a home, it can grow and spread over surfaces such as clothing, leather, or building materials, particularly in moist areas.
FAQ
Though you may hear the terms “mold” and “mildew” used interchangeably, there are some key differences between these two organisms. While mildew is always flat or powdery in appearance with a white or gray color, mold is often raised, fuzzy, or slimy and can be different colors such as black, green, blue, or red.
Another key difference is that mold can burrow beneath the surface, while mildew is a surface fungi that is easier to spot. Mold also poses greater health risks than mildew. In addition to causing respiratory problems, like mildew, mold can also have a negative impact on the nervous system.
Black mold looks like a black stain. It is most often found in areas of higher moisture, particularly in those that have been cleaned after flooding. One of the signs of black mold is a circular growth pattern. Look for round patches growing together; some may be smaller than an inch, with others being much larger. Use a black mold test or schedule an inspection to verify if black mold is present.
While there are some tests designed to identify mold exposure, they are not 100 percent reliable. However, your primary care physician may be able to assess your symptoms and perform blood tests or skin-prick tests to learn more about your sensitivity to mold.
Removing mold on the walls is important, but you also need to know how to detect mold in walls to ensure that the issue is fully remedied. Mold test kits detect mold in the air, so if the mold spores inside the wall are getting into the air, they will be detected. Otherwise, the test kit may not find mold growing inside the walls.
The best way to prevent mold is to control moisture, especially in vulnerable areas of your home, such as bathrooms. That means cleaning up spills, keeping the indoor relative humidity below 60 percent, and repairing any plumbing leaks. Always turn on exhaust fans when cooking or showering, letting them run for 15 to 20 minutes after you’re done with the activity.